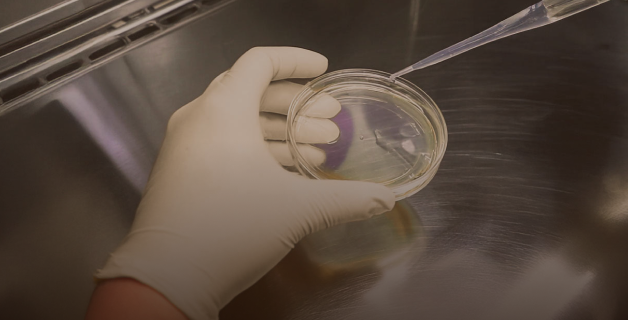
檢驗檢測

-
{{ childProduct.title_translations | translateModel }}
{{ getChildVariationShorthand(childProduct.child_variation) }}
-
{{ getSelectedItemDetail(selectedChildProduct, item).childProductName }} x {{ selectedChildProduct.quantity || 1 }}
{{ getSelectedItemDetail(selectedChildProduct, item).childVariationName }}

企業贈禮
企業贈禮 客製開發
客製開發 異業合作
異業合作 @Renata2014 (一般消費者)
@Renata2014 (一般消費者)







